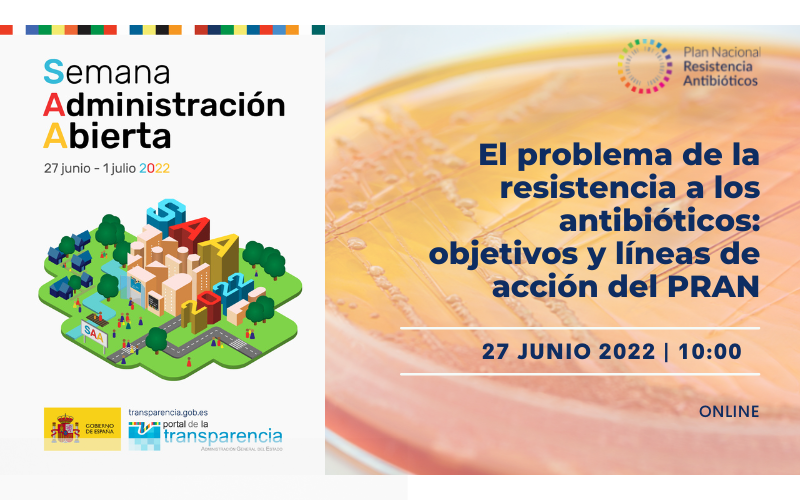

El Plan Nacional frente a la Resistencia a los Antibióticos (PRAN), coordinado por la Agencia Española de Medicamentos y Productos Sanitarios (AEMPS), ha concluido hoy la jornada "El problema de la resistencia a los antibióticos: objetivos y líneas de acción del PRAN", enmarcada dentro de la Semana de la Administración Abierta 2022. Entre los asistentes, ha destacado la presencia del sector de la Sanidad, que representaba el 52% del público.
En este encuentro virtual, se ha dado a conocer la resistencia a los antibióticos a un público general, sin otro fin que promover la transparencia acerca de este problema mediante un mensaje claro y ameno.
Después de que la coordinadora del PRAN en sanidad animal, Cristina Muñoz, abriese esta jornada, Reyes Castillo, de la Unidad de Coordinación del PRAN, ha realizado una introducción sobre el origen de los antibióticos. Tras la intervención, en la que ha explicado el descubrimiento de la penicilina para poner en contexto a la ciudadanía, Amparo Haro, integrante del equipo medioambiental del PRAN, ha desarrollado el problema de las resistencias y la importancia de abordar la resistencia antimicrobiana con una estrategia One Health. Para finalizar, Cristina Muñoz ha presentado las líneas de acción del PRAN y los notables logros alcanzados hasta la fecha.
El evento ha incluido una sesión de preguntas y respuestas, en la cual la Unidad de Coordinación del PRAN ha detallado su participación en los proyectos desarrollados por los organismos internacionales y las instituciones europeas, y la coordinación con las comunidades autónomas, además de hablar sobre las pruebas de diagnóstico en atención primaria, entre otras cuestiones.
Semana de la Administración Abierta 2022
Según los datos de la página web de la Open Gov Week, la Semana de la Administración Abierta ha contado este año con cerca de 750 eventos en todo el mundo, de los cuales 369 se celebraron en España.
Esta iniciativa está impulsada a nivel mundial por la Alianza para el Gobierno Abierto y coordinada e impulsada por la Dirección General de Gobernanza Pública, con la colaboración del Foro de Gobierno Abierto. Durante esta semana, la Administración Pública española y las organizaciones de la sociedad civil han presentado diferentes eventos con el objetivo de reforzar los vínculos entre los poderes públicos y la ciudadanía, poniendo de manifiesto el compromiso de nuestras instituciones con el desarrollo de los valores de la transparencia, la rendición de cuentas, la participación ciudadana y la colaboración de la Administración con la sociedad.
La Semana de la Administración Abierta 2022 ha sido una oportunidad para que la ciudadanía conociese mejor el funcionamiento de la Administración Pública y se familiarizase con los valores del Gobierno Abierto, que han de orientar el desempeño de las responsabilidades públicas y la actuación de las Administraciones.
Información de los eventos
La información de los eventos celebrados durante la Semana de la Administración Abierta está disponible en el espacio web facilitado por la entidad organizadora.